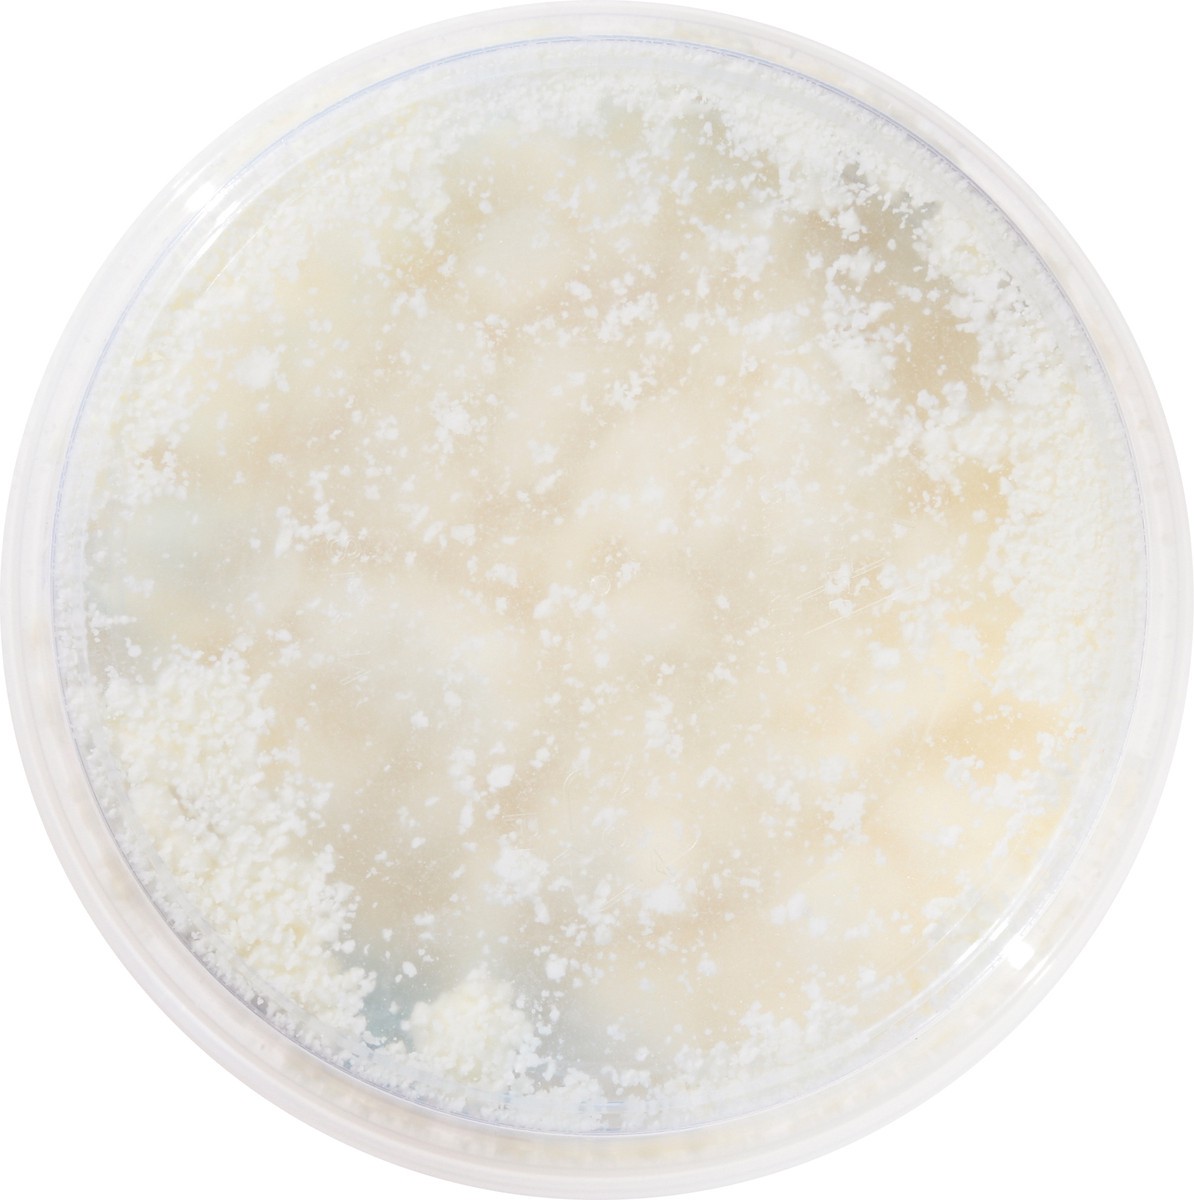
slide 9 of 14, Essential Everyday Crumbled Feta Cheese 6 oz, 6 oz

Essential Everyday
Essential Everyday Crumbled Feta Cheese 6 oz
$3.89
6 oz
Dierbergs
Available in
63119
Looking for the best in Feta Cheese? Try Essential Everyday Crumbled Feta Cheese 6 oz from a trusted brand. This product is crafted to provide creamy goodness, making it a farm-fresh for any household…
Ingredients
Feta Cheese (Cultured Pasteurized Milk, Salt, Enzymes), Powdered Cellulose (to Prevent Caking), Natamycin (a Natural Mold Inhibitor).